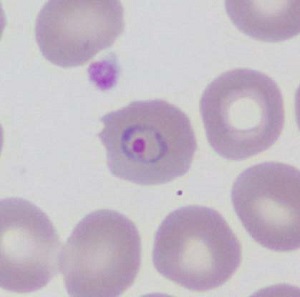
FEBRUARY - 2018 - Case #461 Parasitic image

2018 DPDx Case Studies
DPDx Case Studies - 2018
More Case Studies by Year
December 2018
November 2018
October 2018
September 2018
August 2018
July 2018
June 2018
May 2018
April 2018
March 2018
February 2018
January 2018
DPDx is an educational resource designed for health professionals and laboratory scientists. For an overview including prevention, control, and treatment visit www.cdc.gov/parasites/.